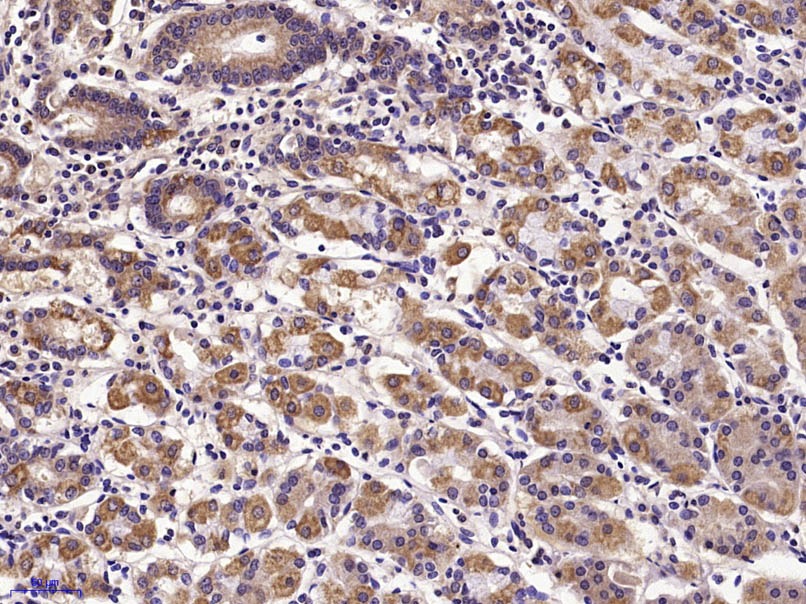
verifiedActivity

购物车
 您的购物车当前为空
您的购物车当前为空
Anti-E-Cadherin/Cadherin-1 Polyclonal Antibody 是一种 Rabbit 抗体,靶向 E-Cadherin/Cadherin-1。Anti-E-Cadherin/Cadherin-1 Polyclonal Antibody 可用于 IF, IHC-Fr, IHC-P, WB。
别名 UVO, LCAM, E-Cadherin, E-cad, ECAD, CDHE, CDH1, CD324, cadherin 1, type 1, E-cadherin (epithelial), Arc-1
Anti-E-Cadherin/Cadherin-1 Polyclonal Antibody 是一种 Rabbit 抗体,靶向 E-Cadherin/Cadherin-1。Anti-E-Cadherin/Cadherin-1 Polyclonal Antibody 可用于 IF, IHC-Fr, IHC-P, WB。
| 规格 | 价格 | 库存 | 数量 |
|---|---|---|---|
| 50 μL | ¥ 1,175 | 5日内发货 | |
| 100 μL | ¥ 1,960 | 5日内发货 | |
| 200 μL | ¥ 2,785 | 5日内发货 |
TargetMol的所有产品仅用作科学研究或药证申报,不能被用于人体,我们不向个人提供产品和服务。请您遵守承诺用途,不得违反法律法规规定用于任何其他用途。
| 产品描述 | Anti-E-Cadherin/Cadherin-1 Polyclonal Antibody is a Rabbit antibody targeting E-Cadherin/Cadherin-1. Anti-E-Cadherin/Cadherin-1 Polyclonal Antibody can be used in IF, IHC-Fr, IHC-P, WB. |
| 别名 | UVO, LCAM, E-Cadherin, E-cad, ECAD, CDHE, CDH1, CD324, cadherin 1, type 1, E-cadherin (epithelial), Arc-1 |
| Ig Type | IgG |
| 反应种属 | Human,Rat (predicted:Mouse,Pig,Cow,Horse,Rabbit) |
| 验证活性 | 1. Paraformaldehyde-fixed, paraffin embedded (Human colon carcinoma); Antigen retrieval by microwave in sodium citrate buffer (pH6.0); Block endogenous peroxidase by 3% hydrogen peroxide for 30 minutes; Blocking buffer (3% BSA) at RT for 30 min; Antibody incubation with (E cadherin) Polyclonal Antibody, Unconjugated (TMAB-00584) at 1:400 overnight at 4°C, followed by conjugation to the secondary antibody (labeled with HRP) and DAB staining. 2. Sample: HT29 (Human) Cell Lysate at 30 μg PC-3 (Human) Cell Lysate at 30 μg Primary: Anti-E cadherin (TMAB-00584) at 1/1000 dilution Secondary: IRDye800CW Goat Anti-Rabbit IgG at 1/20000 dilution Predicted band size: 20/80 kDa Observed band size: 130 kDa 3. Paraformaldehyde-fixed, paraffin embedded (Human stomach); Antigen retrieval by microwave in sodium citrate buffer (pH6.0); Block endogenous peroxidase by 3% hydrogen peroxide for 30 minutes; Blocking buffer (3% BSA) at RT for 30 min; Antibody incubation with (E cadherin) Polyclonal Antibody, Unconjugated (TMAB-00584) at 1:400 overnight at 4°C, followed by conjugation to the secondary antibody (labeled with HRP) and DAB staining. 4. Sample: Lane 1: A431 (Human) Cell Lysate at 30 μg Lane 2: A549 (Human) Cell Lysate at 30 μg Lane 3: HepG2 (Human) Cell Lysate at 30 μg Primary: Anti-E cadherin (TMAB-00584) at 1/1000 dilution Secondary: IRDye800CW Goat Anti-Rabbit IgG at 1/20000 dilution Predicted band size: 125 kDa Observed band size: 125 kDa 5. Paraformaldehyde-fixed, paraffin embedded (rat spinal cord); Antigen retrieval by boiling in sodium citrate buffer (pH6.0) for 15 min; Block endogenous peroxidase by 3% hydrogen peroxide for 20 min; Blocking buffer (normal goat serum) at 37°C for 30 min; Antibody incubation with (E cadherin) Polyclonal Antibody, Unconjugated (TMAB-00584) at 1:200 overnight at 4°C, followed by operating according to SP Kit (Rabbit) instructionsand DAB staining. 6. Paraformaldehyde-fixed, paraffin embedded (rat liver); Antigen retrieval by boiling in sodium citrate buffer (pH6.0) for 15 min; Block endogenous peroxidase by 3% hydrogen peroxide for 20 min; Blocking buffer (normal goat serum) at 37°C for 30 min; Incubation with (E cadherin) Polyclonal Antibody, Unconjugated (TMAB-00584) at 1:200 overnight at 4°C, followed by operating according to SP Kit (Rabbit) instructionsand DAB staining. 7. Paraformaldehyde-fixed, paraffin embedded (human colon); Antigen retrieval by boiling in sodium citrate buffer (pH6.0) for 15 min; Block endogenous peroxidase by 3% hydrogen peroxide for 20 min; Blocking buffer (normal goat serum) at 37°C for 30 min; Incubation with (E cadherin) Polyclonal Antibody, Unconjugated (TMAB-00584) at 1:200 overnight at 4°C, followed by operating according to SP Kit (Rabbit) instructionsand DAB staining. |
| 应用 | IFIHC-FrIHC-PWB |
| 推荐剂量 | IF=1:200-800; IHC-Fr=1:200-800; IHC-P=1:200-800; WB=1:1000-5000 |
| 抗体种类 | Polyclonal |
| 宿主来源 | Rabbit |
| 亚细胞定位 | Cell junction. Cell membrane; Single-pass type I membrane protein. |
| 组织特异性 | Non-neural epithelial tissues. |
| 构建方式 | Polyclonal Antibody |
| 纯化方式 | Protein A purified |
| 性状 | Liquid |
| 缓冲液 | 0.01M TBS (pH7.4) with 1% BSA, 0.02% Proclin300 and 50% Glycerol. |
| 浓度 | 1 mg/mL |
| 研究背景 | This gene encodes a classical cadherin of the cadherin superfamily. Alternative splicing results in multiple transcript variants, at least one of which encodes a preproprotein that is proteolytically processed to generate the mature glycoprotein. This calcium-dependent cell-cell adhesion protein is comprised of five extracellular cadherin repeats, a transmembrane region and a highly conserved cytoplasmic tail. Mutations in this gene are correlated with gastric, breast, colorectal, thyroid and ovarian cancer. Loss of function of this gene is thought to contribute to cancer progression by increasing proliferation, invasion, and/or metastasis. The ectodomain of this protein mediates bacterial adhesion to mammalian cells and the cytoplasmic domain is required for internalization. This gene is present in a gene cluster with other members of the cadherin family on chromosome 16. [provided by RefSeq, Nov 2015] |
| 免疫原 | KLH conjugated synthetic peptide: human E-cadherin |
| 抗原种属 | Human |
| 基因名称 | CDH1 |
| 基因ID | |
| 蛋白名称 | Cadherin-1 |
| Uniprot ID | |
| 研究领域 | Cadherins,Kidney development,e cadherin,Cadherins,Calcium Binding Proteins |
| 功能 | Cadherins are calcium-dependent cell adhesion proteins. They preferentially interact with themselves in a homophilic manner in connecting cells; cadherins may thus contribute to the sorting of heterogeneous cell types. CDH1 is involved in mechanisms regulating cell-cell adhesions, mobility and proliferation of epithelial cells. Has a potent invasive suppressor role. It is a ligand for integrin alpha-E/beta-7. E-Cad/CTF2 promotes non-amyloidogenic degradation of Abeta precursors. Has a strong inhibitory effect on APP C99 and C83 production. |
| 分子量 | Theoretical: 90/97 kDa. Actual: 125 kDa. |
| 储存方式 | Store at -20°C or -80°C for 12 months. Avoid repeated freeze-thaw cycles. |
| 运输方式 | Shipping with blue ice. |